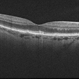
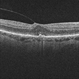

-
 By McGill University Health Centre
By McGill University Health Centre
The MUHC-McGill University
Co-author(s): Sabrina Bergeron, P. Zoroquiain, E. Esposito, S. Corredor Casas, P. Logan, A. N. Odashiro, Miguel N. Burnier, Paulina García de Alba Graue, McGill University Health Center-McGill University Ocular Pathology & Translational Research Laboratory - Uploaded on May 18, 2020.
- Last modified by Caroline Bozell on May 19, 2020.
- Rating
- Appears in
- Enucleated Eye
- Condition/keywords
- atrophy, vitreomacular traction (VMT), keratoconus
- Description
- This enucleation specimen shows areas of retinal atrophy (*) and areas of vitreomacular traction (arrow). This specimen also demonstrates keratoconus: a degenerative disorder of the eye in which the cornea thins and distorts into a pronounced conical shape (arrowhead). The keratoconus and vitreomacular tractions are unrelated.


 Initializing download.
Initializing download.